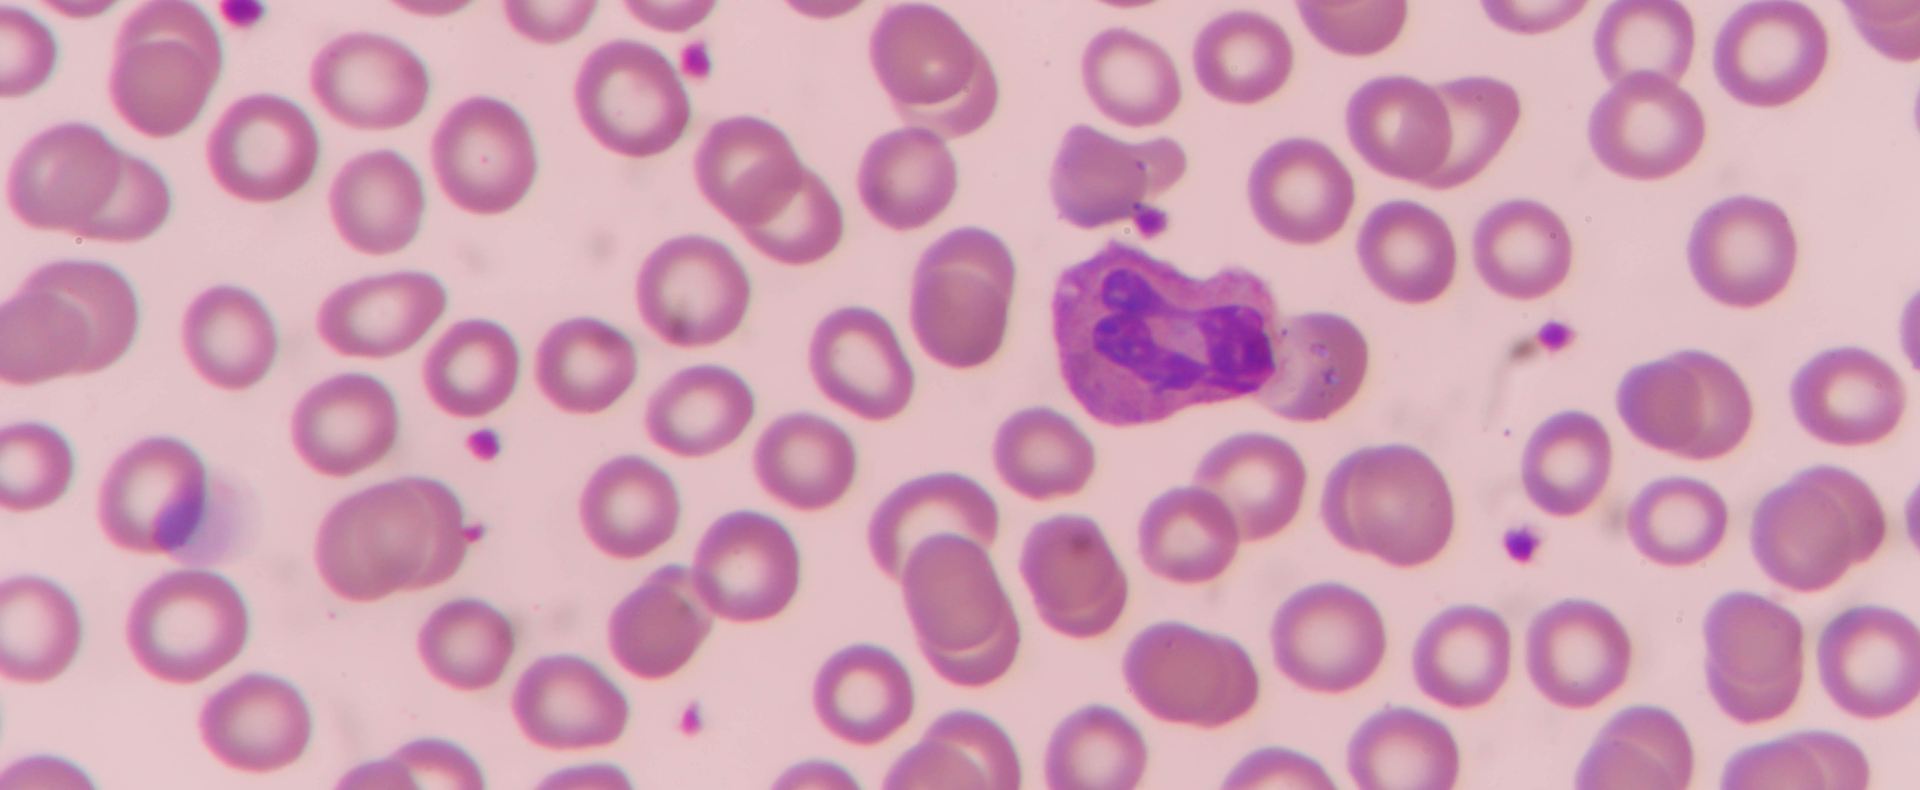
Optimed Sağlık Grubu - Sağlığınız Güvende

Modern tıbbi teknolojilerin, alanında uzman hekimlerle buluşarak nitelikli sağlık hizmetine dönüşümü...
Amacımız; hasta haklarına saygılı, etik değerlere bağlı bir sağlık kuruluşu olarak bugüne kadar tesis ettiğimiz güvene dayalı iletişimi sürdürmek, teknolojik ve bilimsel gelişmeleri hastalarımızın hizmetine sunmak, hasta memnuniyetini en üst düzeyde sağlamak ve çalışanlarımızla bütünleşerek halkımıza layık, kesintisiz bir sağlık hizmeti sunmaya kararlılıkla devam etmektir.
 tr
tr